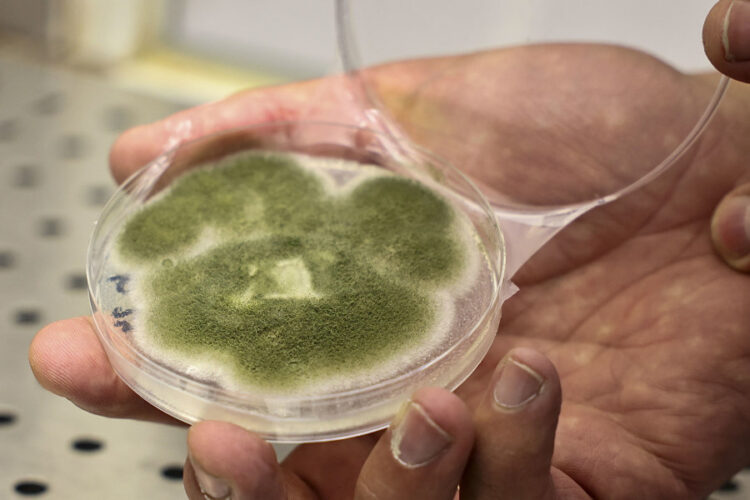

España investiga proteínas generadas por fermentación para viajar a Marte
San Sebastián (España) (EFE).
Un moho filamentoso no es precisamente una palabra que evoque la suculencia culinaria, pero este tipo de hongos microscópicos son auténticas máquinas de generar proteínas de calidad mediante la fermentación, y la NASA ya ha puesto los ojos en ellos como intendencia para viajes a Marte.
Parece ciencia ficción, pero es uno de los proyectos que se estudiará en la primera edición del máster Food Fermentation, que impartirá Basque Culinary Center (BCC, San Sebastián, España) a partir del 3 de noviembre, coordinado por el doctor en Química Aplicada por la Universidad Autónoma de Madrid Cipriano Carrero.

“No existe un curso similar en el mundo”, explica en una entrevista con EFE, y detalla que el curso cuenta con un 50 % de contenido científico técnico, un 25 % de cultura de la fermentación en diferentes entornos y el resto se centra en la parte gastronómica propiamente dicha con el diseñó de nuevos alimentos.
Carrero codirige con la Ames Research Center -un centro de investigación de la NASA que ha participado en misiones espaciales- la tesis de la italiana Alessandra Massa, profesora de desarrollo y tecnología de alimentos de BCC, sobre el crecimiento de los hongos filamentosos mediante la fermentación y sus aplicaciones gastronómicas.

Generadores de proteínas
El campo que abre la fermentación es inmenso y su aplicación como generadora de proteínas de calidad puede ser valioso, no solo en el espacio, sino en momentos de catástrofes como las causadas por un huracán o un terremoto.
“Por ejemplo, si solo hay hojas que no sean tóxicas, podrían convertirse en proteínas tras ese trabajo que realiza un moho filamentoso”, explica Carrero.
La fermentación, el proceso que ocurre en ausencia de oxígeno en el que microorganismos descomponen sustancias orgánicas complejas y las transforman en etanol o ácido acético, se ha utilizado desde hace siglos en todo el mundo.
“Este es el concepto tradicional para un biólogo como yo de lo que es fermentar, pero en el ámbito gastronómico es más amplio. En este campo, los reyes no son los microorganismos sino la propias encimas que son las encargadas de llevarlo a cabo”, precisa.
Por ejemplo, en el ‘garum’ -la salsa de pescado fermentado utilizada desde la época de los romanos-, son las encimas del estómago de los peces las responsables de la fermentación.

Sucede también en la curación del jamón, aunque los consumidores no sean conscientes de ello.
“A la deshidratación se suman las encimas del músculo del cerdo que se comportan como pequeños esclavos que siguen trabajando” hasta que el resultado es el jamón curado.
“Todo organismo puede fermentar o ser fermentado. La única condición que debe cumplir es que sea seguro desde el punto de vista sanitario y que su sabor sea agradable”, comenta.
En este sentido, Carrero incide en el componente cultural que tiene el gusto de un alimento.

El ‘sustromming’ sueco -arenque fermentado- produce rechazo por su olor pestilente para las personas que no están acostumbradas, pero está considerado una delicia en el país escandinavo, mientras algo habitual en nuestras despensas como el queso roquefort es rechazado por los paladares chinos.
“La línea entre lo podrido y lo exquisito es algo impuesto por la sociedad. Así es que, mientras no sea tóxico, ¡adelante!”, anima.
El abanico es amplio, ya que la fermentación con encimas es capaz de conseguir una “explosión de nuevos sabores y colores en alimentos de forma rápida y con pocos recursos”.

Otro ejemplo de ello es el proyecto que lleva a cabo en BCC la mexicana Laura Ann, que elabora mediante la fermentación de semillas y leguminosas con diferentes microorganismos un “chocolate sin cacao”, lo que reduce el impacto mdioambiental de su cultivo.
Además estos alimentos pueden resultar más saludables, ya que están “predigeridos”, explica Carrero.
“Un miso (una pasta japonesa fermentada) es mucho más digestivo que los granos de soja o cebada en estado natural”, remarca el biólogo, que incide en que, además, los productos resultantes de una fermentación aportan microroganismos que transforman los almidones en compuestos con funciones probióticas.
Mercedes Zabaleta



